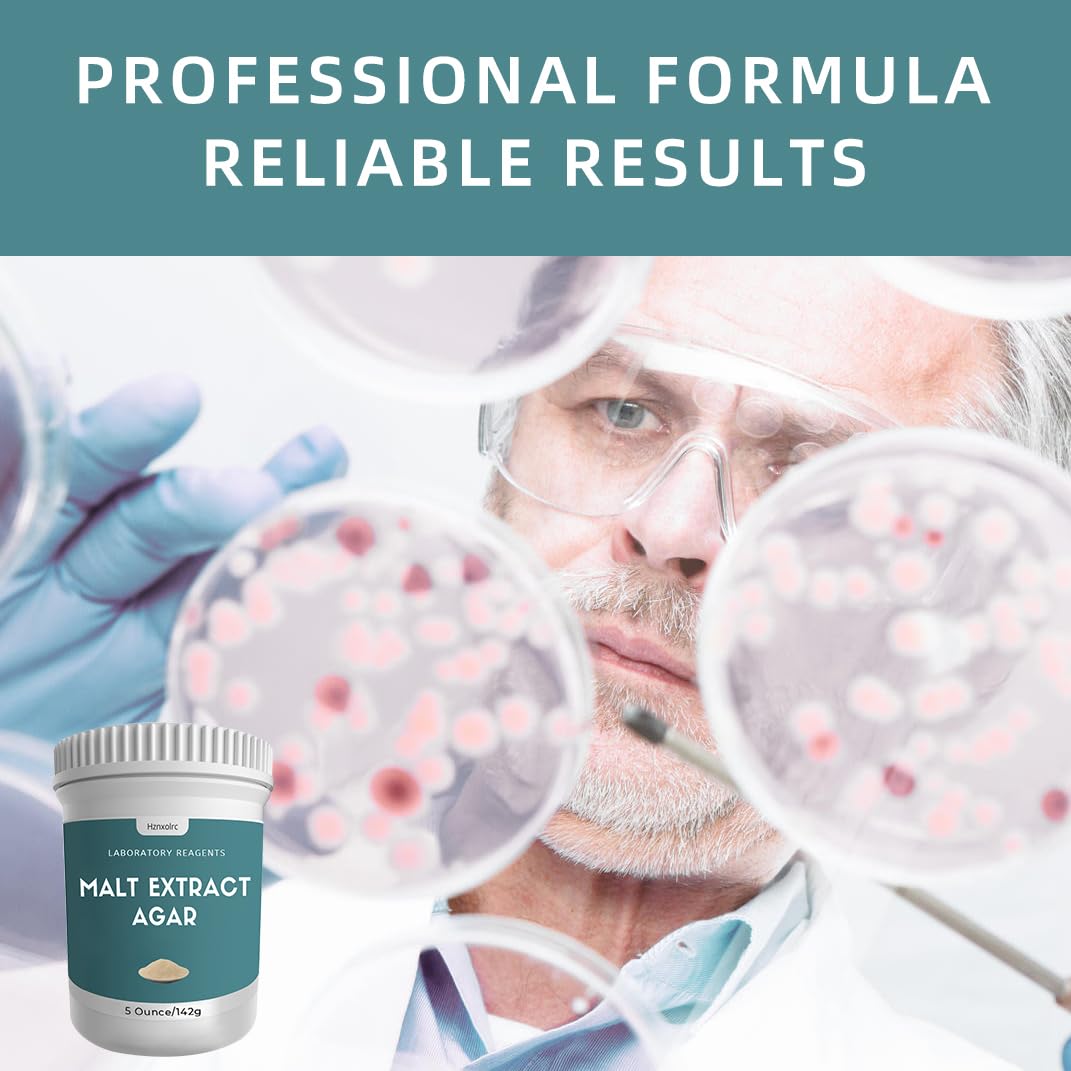
Thumbnail 4

Product DescriptionHznxolrc is committed to providing innovative high quality products and services that meet or exceed the expectations of our customers. Based on customer needs, Hznxolrc developed this malt extract agar powder. We provide 100% satisfactory service. If you are not completely satisfied with the product you purchased, we will give you a full refund. Please rest assured to buy.Why Choose Us?⭐Lower Cost - Produce larger quantities of agar plates.⭐Precise Formulation - Supports robust growth.⭐Lgniting A Passion for Science - Unleash your child's inner scientist.⭐Trusted Quality - Testing and quality control that far exceeds industry standards.⭐Satisfied Guarantee - 100% Full Money Back Guarantee.Package Includes:1 x Plastic spoon1 x 5 oz Malt Extract Agar Powder 1 x Practical package with a lidFast and Effective ResponseFeel free to help you resolve if you have any questions, we will provide you with a very fast and effective response! If you’re not satisfied about our Malt Extract Agar Powder, we offer a money-back service.
Trustpilot
2 months ago
4 days ago